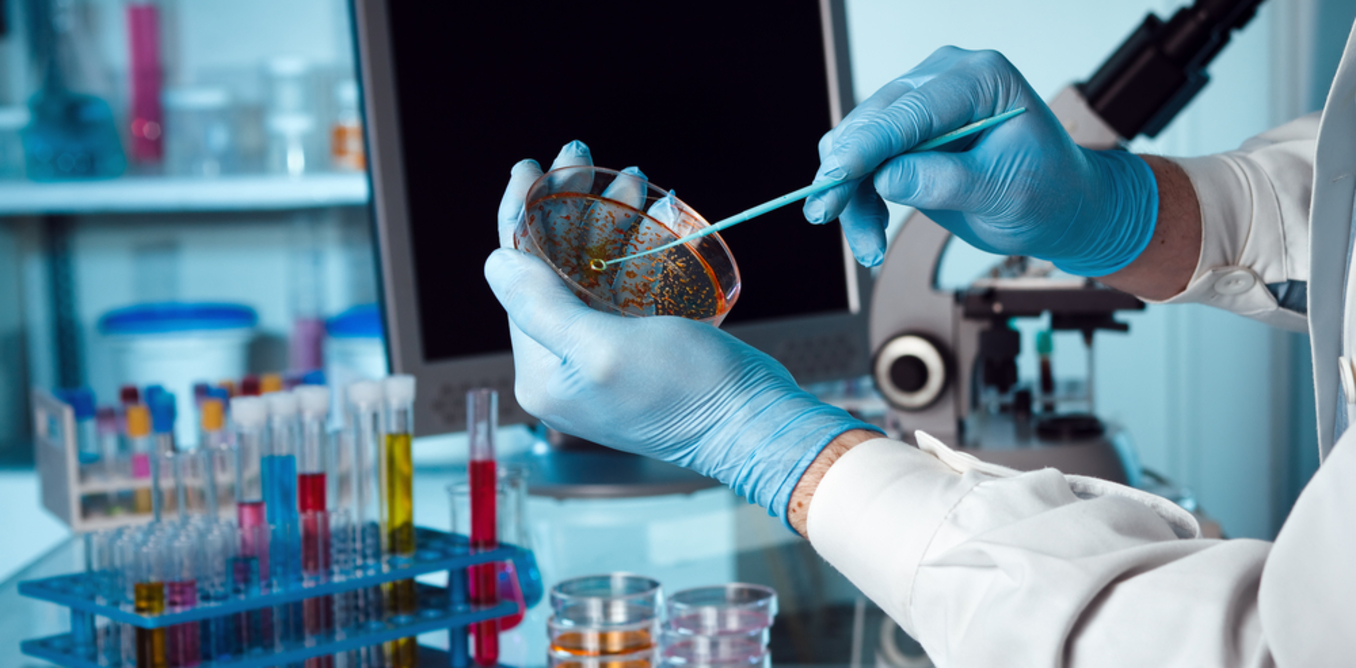
main-post-cover

Tibb sahəsindəki süni zəka startapı Babylon, 60 milyon dollar investisiya aldı (VİDEO)
Babylon adlı startapın yaratdığı süni zəka, xəstənin simptomlarını analiz edərək müəyyən hallarda hansı tədbirlərin görüləcəyini müəyyən edir.
Bu ilin Yanvar ayından startapın yaratdığı süni zəka çat
botu, İngiltərənin milli səhiyyə xidmətinin qaynar xəttində çalışır. Startap,
süni zəka əsasında yaradılmış çat bot həkimin təkmilləşdirilməsi üçün daha 60
milyon dollar investisiya əldə edib. Süni zəka alqoritmi artıq mütəxəssis
iştirakı olmadan xəstəliyi müəyyən edə və sağlamlıqla bağlı problemin nə dərəcədə
real olduğunu müəyyənləşdirə bilir. Babylon-nun yaratdığı texnologiyadan bütün
dünya üzrə artıq 800.000 insan istifadə edir. Startap, 2015-ci ilin Fevral
ayında təsis edilmişdi. İlk mərhələdə virtual həkim, xəstənin vəziyyətini, onun
simptomlarını müəyyən etməyi və dərmanların vaxtı-vaxtında qəbul olunmasını, xəstənin
yadına salınmasını öyrənib. Müayinə zamanı o, xəstəyə bir neçə suallar verir.
Həmin sualların cavabları əsasında müəyyən simptomlar
zamanı hansı tədbirlərin görülməsinin lazım olduğu müəyyən edilir. Bu ilin Mart
ayında Babylon öz texnologiyasını təkmilləşdirdi. Artıq startapın, diaqnoz təyin
edə bilən xüsusi tətbiqi mövcuddur. Onu sadəcə olaraq smartfona yükləmək kifayətdir.
Startapın təsisçiləri düşünürlər ki, beləliklə həkimlər süni zəka ilə birlikdə
çalışaraq müayinəyə çox vaxt itirmədən əsas diqqəti müalicə prosesinə
ayıracaqlar. Sözügedən tətbiq həmçinin smartfon vasitəsilə həkimlə ödənişli
videokonfransların təşkil olunmasını da təklif edir. Bu xidmətin aylıq abunə
haqqı 5 avro təşkil edir. Lakin əgər hansısa şəxs bir dəfə həkimlə konsultasiya
keçirtmək istəsə, onda o, 25 avro ödəməli olacaq. Qeyd etmək lazımdır ki, canlı
şəkildə həkimlə görüş daha baha başa gələ bilər. Keçən ilin əvvəlində isə bu
startap, Avropanın rəqəmsal tibb sahəsi tarixində ən böyük investisiyanı (25
milyon dollar) almışdı.
Paylaş
Bənzər xəbərlər